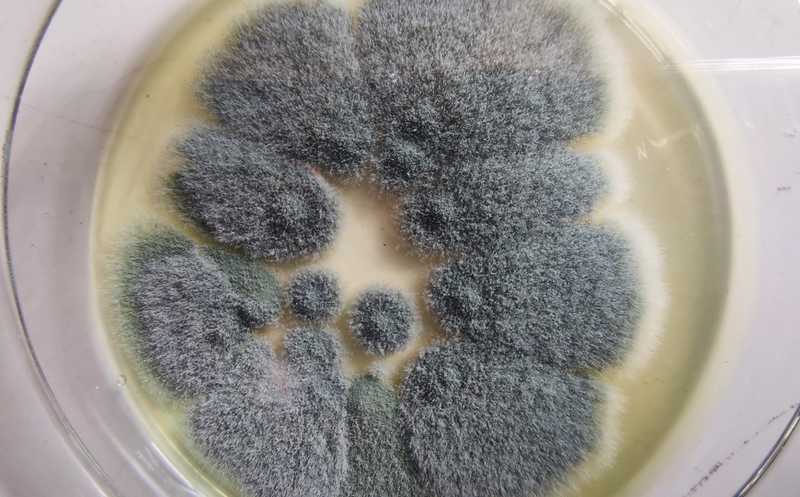

Резистентный патогенный грибок распространяется по Великобритании из-за движения воздушных масс
Исследователи из Великобритании попросили помощи у волонтеров, чтобы собрать образцы воздуха по всей стране в течение года. Они проанализировали распространенность и свойства плесневого грибка Aspergillus fumigatus, который вызывает аспергиллезы у человека и известен резистентностью к препаратам первой линии. По мнению ученых, распределение устойчивых вариантов подтверждает гипотезу о развитии резистентности из-за широкого применения противогрибковых веществ, схожих с медицинскими препаратами, в сельском хозяйстве.
Aspergillus fumigatus — это широко распространенный плесневый грибок, который может стать причиной развития инфекции у людей. К сожалению, этот вид постепенно приобретает резистентность к противогрибковым препаратам первой линии, например, к азолам. Предположительно, это происходит из-за применения похожих соединений в сельском хозяйстве. Развиваясь в условиях повышенной концентрации фумицидов, гриб приобретает резистентность к азолам и становится невосприимчивым к первой линии противогрибковых препаратов.
Несмотря на актуальность проблемы, до сих пор не появлялось исследований о распространении A. fumigatus в течение года. Исследователи из Великобритании изучили этот вопрос. Для сбора образцов по всей стране они привлекали волонтеров. Благодаря этому авторы отобрали 1894 пробы микроорганизмов воздуха по всей Великобритании с лета 2018 года по весну 2019 года.
Чтобы выделить A. fumigatus, авторы культивировали пробы в селективных условиях при высокой температуре (43ºС). В итоге 49% проб дали начало 2366 колониям. Проверив грибы на устойчивость к противогрибковым препаратам, авторы показали, что 4,7% колоний резистентны к сельскохозяйственному фунгициду тебуконазолу. Среди этих колоний 18–86% грибов также были нечувствительны к различным медицинским азолам. Ученые считают, что этот результат еще раз доказывает ранее предложенную гипотезу о механизме развития резистентности у A. fumigatus.
Затем авторы изучили геном грибов, которые были устойчивы к фунгицидам. Они сфокусировались на гене стеролдеметилазы cyp51A, который уже ранее обсуждался в литературе. Оказалось, что в большинстве случаев (59%) резистентность обусловлена заменой лейцина на гистидин в промоторной области гена. Интересно, что около 30% резистентных грибов не содержали никаких мутаций в cyp51A. Авторы предполагают, что существует другой механизм развития устойчивости, который не связан с стеролдеметилазой.
Также ученые проанализировали географическое распределение резистентных грибков. Для этого они изучили образцы почвы для того же временного промежутка и сравнили их с образцами воздуха. Оказалось, что в 50% случаев (23 из 46) резистентные грибы присутствовали только в одном из образцов и лишь для 7% случаев устойчивые грибки присутствовали как в воздухе, так и в почве. Этот результат, считает ученые, доказывает, что движение воздушных масс играет важную роль в распространении спор. Таким образом, все жители Великобритании, независимо от близости к очагу развития резистентности, в равной мере подвержены воздействию устойчивых вариантов A. fumigatus.
Пациенты из группы риска могут заражаться резистентным грибком из окружающей среды
Источник:
Jennifer M.G. Shelton, et al. Citizen science reveals landscape-scale exposures to multiazole-resistant Aspergillus fumigatus bioaerosols. // Science Advances. 2023. DOI: 10.1126/sciadv.adh8839


 Меню
Меню





 Все темы
Все темы




 0
0











